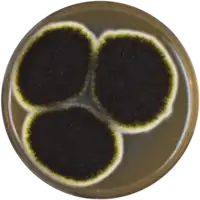

افشانکچه
افشانکچه یا آسپرژیلوس (Aspergillus) یک سرده شامل چندصد گونه از کپک است که در اقلیمهای متنوع آب و هوایی در سرتاسر جهان یافت میشود. افشانکچه را نخستین بار یک کشیش و زیستشناس ایتالیایی به نام پییر انتونیو میچلی کشف کرد. او با دیدن این قارچ در زیر ریزبین بخاطر شباهت آن با آب افشانی که در مراسم مذهبی آسپرژیلیوم خوانده میشد نام آسپرژیلوس برای این گونه برگزید.[1] افشانکچه تولید مثل غیرجنسی دارد و اینکار را با ساخت هاگ انجام میدهد و این ویژگی در میان همهٔ اعضای این گونه مشترک است. در حدود یک سوم ازین گونهها همچنین به مرحله ای از ساختار جنسی نیز میرسند. برخی گونههای آن بیماریزا و برخی دیگر دارای کاربرد صنعتی و غذایی میباشند.
| افشانکچه | |
|---|---|
![]() | |
| Conidial head of Aspergillus niger | |
| آرایهشناسی | |
| فرمانرو: | قارچ |
| شاخه: | قارچهای کیسهای |
| رده: | یوروتیومیستس |
| راسته: | Eurotiales |
| تیره: | Trichocomaceae |
| سرده: | افشانکچه |

آسپرژیلوس فلاووس، آسپرژیلوس پارازیتیکوس و آسپرژیلوس فومیگاتوس گونههای بیماریزا بوده و آسپرژیلوس نایجر و آسپرژیلوس اورایزا گونههای مفید آن هستند.
گونهها
آسپرژیلوس اورایزا
در فرآوری سویا «آسپرژیلوس اورایزا» مهمترین ریزاندامگان (میکروارگانیسم) تولیدکننده آنزیمهای لازم است که در ایجاد عطر و طعم دخالت دارد. همچنین در این قارچ در تولید برخی از آنزیمهای مورد نیاز در ژنتیک مولکولی کاربرد دارد.
منابع
- Bennett JW (2010). "An Overview of the Genus Aspergillus" (PDF). Aspergillus: Molecular Biology and Genomics. Caister Academic Press. ISBN 978-1-904455-53-0.
- فرشته زارعی، محمد منصوری (۱۳۹۳). کتاب جامع قارچشناسی IQB. تهران: گروه تألیفی دکتر خلیلی. صص. ۱۶۵. شابک ۹۷۸-۶۰۰-۶۲۲۳-۷۶-۶.
ویکیپدیای انگلیسی